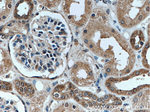
TOMM22 Antibody in Immunohistochemistry (Paraffin) (IHC (P))

Search
Proteintech
TOMM22 Monoclonal Antibody (1C2B11)
{{$productOrderCtrl.translations['antibody.pdp.commerceCard.promotion.promotions']}}
{{$productOrderCtrl.translations['antibody.pdp.commerceCard.promotion.viewpromo']}}
{{$productOrderCtrl.translations['antibody.pdp.commerceCard.promotion.promocode']}}: {{promo.promoCode}} {{promo.promoTitle}} {{promo.promoDescription}}. {{$productOrderCtrl.translations['antibody.pdp.commerceCard.promotion.learnmore']}}
产品信息
66562-1-IG
种属反应
宿主/亚型
分类
类型
克隆号
抗原
偶联物
形式
浓度
规格
纯化类型
保存液
内含物
保存条件
运输条件
产品详细信息
66562-1-Ig recognizes a22 kDa protein that is larger than the calculated MW of 15 kDa.
Immunogen sequence: MAAAVAAAG AGEPQSPDEL LPKGDAEKPE EELEEDDDEE LDETLSERLW GLTEMFPERV RSAAGATFDL SLFVAQKMYR FSRAALWIGT TSFMILVLPV VFETEKLQME QQQQLQQRQI LLGPNTGLSG GMPGALPSLP GKI (1-142 aa encoded by BC009363)
靶标信息
Tom22 has a negatively charged N-terminal region exposed to the cytosol, a putative transmembrane region, and a C-terminal intermembrane space region with little negative charge. The following functions can be assigned to the three domains of Tom22: the cytosolic N-terminal domain plays a dual role, specifically important for presequence binding; the intermembrane space domain provides a trans binding site for presequences, and the single membrane anchor of Tom22 is crucial for the integrity of the GIP (general import gene) complex. The TOM complex of mammalian mitochondria resembles the fungal Tom complex, but is distinct from the plant TOM system. Thus, while unique components of the mammalian mitochondrial import system have been identified (e. g. TOM34 and metaxin), Tom22, and Tom37 have not been identified in plant mitochondria.
仅用于科研。不用于诊断过程。未经明确授权不得转售。
生物信息学
蛋白别名: 1C9-2; dJ508I15.5; hTom22; Mitochondrial import receptor subunit TOM22 homolog; mitochondrial import receptor Tom22; Translocase of outer membrane 22 kDa subunit homolog; translocase of outer mitochondrial membrane 22 homolog; unnamed protein product
基因别名: 1C9-2; MST065; MSTP065; TOM22; TOMM22
UniProt ID: (Human) Q9NS69
Entrez Gene ID: (Human) 56993